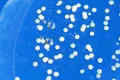
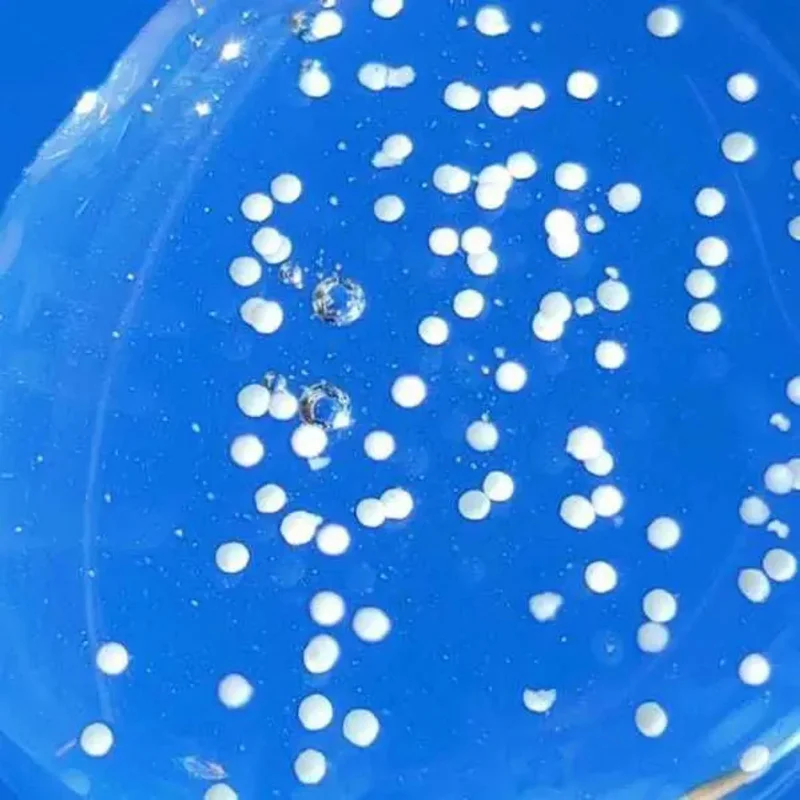

چسب پلمپ جعبه باز شده و جعبه دارای مقداری اسیب دیدگی میباشد.
✨ SKIN1004 : Madagascar Centella Tone Brightening Capsule Ampoule ✨
✨ آمپول روشنکننده کپسولی سنتلا ماداگاسکار اسکین 1004 ✨
✨۱۰۰ میل✨
✨ این محصول یک آمپول روشنکننده و ضدلک تخصصی با عملکردهای اصلی زیر است 👇🏻
_ روشنکنندگی پوست، برطرف و کمرنگتر کردن لَکهای پوستی و نقاط تیره پوست از جمله قرمزی و لک جای جوش، کک و مک، ملاسما، لکهای خورشیدی و … ✨
_ رطوبترسانی، افزایش و حفظ رطوبت پوست و جلوگیری از خشکی و دهیدراتگی آن💧
_ احیاکنندگی و شادابکنندگی پوستهای کدر و خسته ✨💆🏻♀️
_ تسکیندهندگی و التیامبخشی پوست و رفع قرمزی و التهاب 🍀
_ کمک به رفع و جلوگیری از چینو چروکهای پوستی، افزایش خاصیت ارتجاعی پوست و جلوگیری از افتادگی آن با افزایش سنتز کلاژن 💆🏻♀️
_ تسکیندهندگی، حفظ سلامت و جلوگیری از آسیبدیدگی پوست توسط عوامل آسیبرسان محیطی و رادیکالهای آزاد با ترکیبات آنتیاکسیدان🧪
✨ این آمپول علاوه بر ترکیبات تخصصی برای روشنکنندگی و از بینبردن رنگدانههای اضافی پوست، برای جلوگیری از ایجاد هرگونه حساسیت، التهاب و آسیب، دارای ترکیبات تسکیندهنده، تقویتکننده سددفاعی-رطوبتی و رطوبترسان نیز میباشد و تا حد قابل توجهی به افزایش سطح سلامت و شادابی پوست کمک میکند.✨💧🍀
✨ ترکیبات اصلی به کار رفته در این محصول عبارتند از 👇🏻
_ کمپلکس عصاره خالص گیاه سنتلا آسیاتیکا ماداگاسکار به همراه مادکاسوساید و مشتقات دیگر به دست آمده از آن با خواص تسکیندهندگی و التیامبخشی پوست، کاهش التهابات پوستی، کمک به تقویت و ترمیم سددفاعی پوست و مراقبت از پوست در برابر عوامل محیطی و کاهش حساسیتها.🍀🧪
_ نیاسینامید (ویتامین B3) با خواص روشنکنندگی ، از بین بردن لکهای پوستی، یکدستکنندگی تناژ پوست، کنترل چربی و سایز منافذ، افزایش سلامت پوست، جلوگیری از ایجاد چین و چروک و پیری آن✨🧪
این ترکیب به علت جلوگیری از حرکت ملانین (رنگدانه های پوستی) به سطح پوست، باعث روشنکنندگی تناژ پوست ، از بین بردن لکهای پوستی و جای جوش میشود و با کنترل میزان چربی پوست به رفع مشکلات پوستی کمک میکند✨💆🏻♀️
_ ترنکسامیکاسید با خاصیت روشنکنندگی، کاهش تولید ملانین، کمک به رفع لکهای پوستی و تیرگی پوست✨
_ ویتامین C به فرم 3-O-Ethyl Ascorbic Acid برای روشنکنندگی و کاهش ملانین اضافی پوست با خاصیت آنتیاکسیدانی🍊
_پنتنول (ویتامین B5) با اثر مرطوب کنندگی، تسکین دهندگی و ترمیم سد دفاعی پوست 💧
_ لایزات تخمیری به دست آمده از باکتری لاکتوباسیلوس. این ترکیب باعث ترمیم و تقویت سددفاعی پوست، تغذیهکنندگی، افزایش رطوبت پوست، افزایش میزان سلامت پوست و افزایش خاصیت ارتجاعی و کاهش چین و چروکهای پوست میشود.🔬🧫🧪
👈🏻 دارای بافت شفاف و نسبتا غلیظ، دارای کپسولهای سفید قابل مشاهده که روی پوست باز و جذب میشوند، کاملا زود جذب و بدون ایجاد احساس سنگینی و چسبندگی روی پوست💧
👈🏻 دارای تاییدیه از تستهای عدم ایجاد حساسیت ✅
👈🏻 مناسب برای انواع پوست، حتی پوستهای حساس ✅
👈🏻 فاقد ترکیبات شیمیایی مضرر و حساسیتزا ❌
👈🏻 طریقه استفاده : پس از استفاده از تونر، مقدار مناسبی از آمپول را روی پوست صورت پخش کنید.

این محصولتون کی شارژ میشه ؟
514 روز پیش ارسال پاسخدیدگاه خود را بنویسید